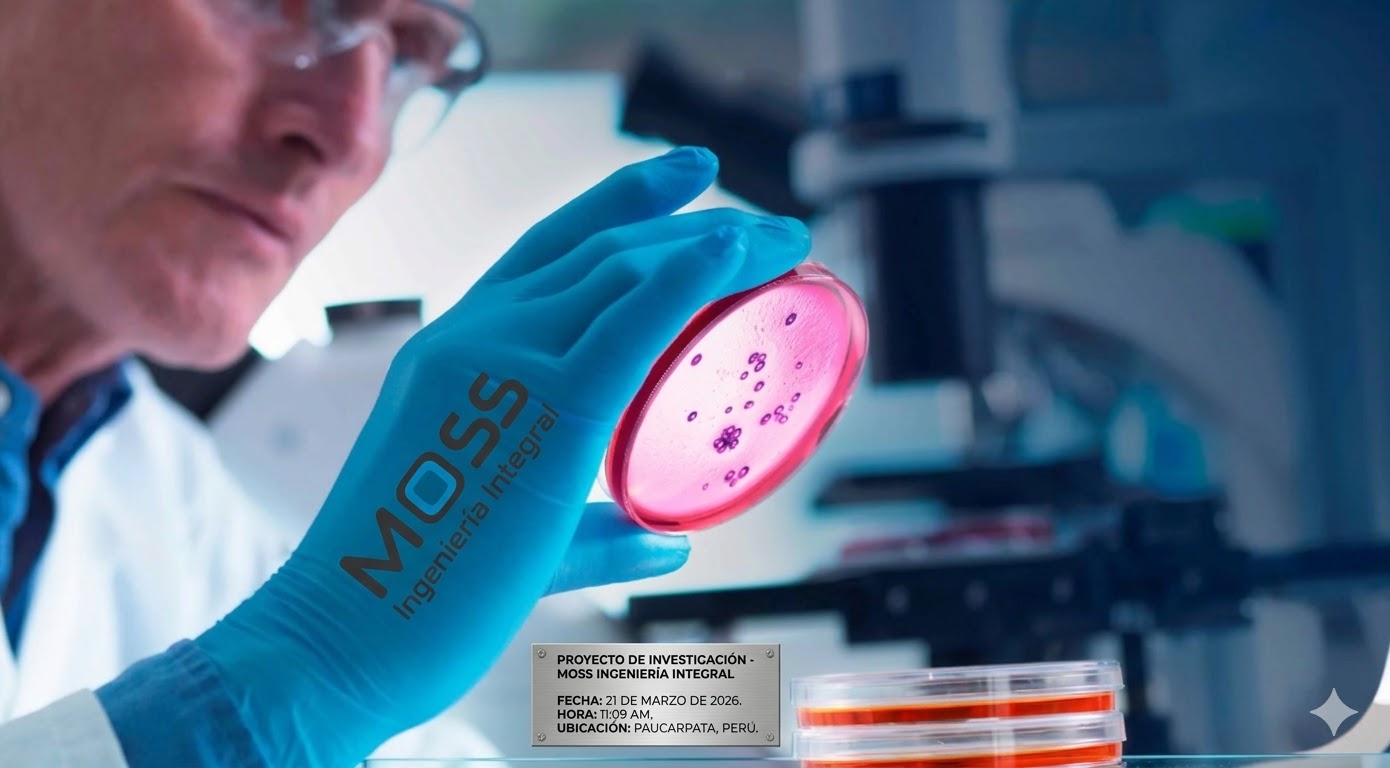
Vida Ciencias

Grupo MOSS convierte las necesidades de sus clientes en soluciones de ingeniería con calidad, economía y plazo deseado. Consultoría y ejecución de proyectos eléctricos, mecánicos, industriales y civiles.
Nuestros servicios

Consultoría y Gerenciamiento ›
Combinamos nuestra experiencia global y conocimiento de la industria para ofrecer servicios profesionales de planificación, gestión de costos, licitaciones, supervisión técnica de obras, comisionamiento y puesta en marcha de proyectos a la medida de cada cliente.

Ejecución de Proyectos ›
Evaluación y ejecución integral de proyectos eléctricos, obras civiles, industriales, electrónica y telecomunicaciones, mecánica, logística y sustentabilidad ambiental. Atendemos a MYPES, mediana y gran empresa en todos los sectores productivos del Perú, Bolivia y Chile.

Mantenimiento Integral ›
Servicios especializados en mantenimiento de instalaciones, equipos, estructuras metálicas, tanques y superficies industriales. Operamos en áreas clasificadas de alto riesgo, espacios confinados y zonas con presencia de H₂S bajo los más altos estándares de seguridad.
Servicios y experiencia
Líneas de negocio destacadas
Acerca de MOSS
A través de nuestra gente, proyectos y asociaciones, MOSS conecta empresas y comunidades para impulsar economías y empleo. Generamos opciones y oportunidades a nivel local y global.
Construir un mundo mejor es nuestro propósito. Nos importa profundamente la seguridad y buscamos fomentar la calidad y la eficiencia en todo lo que hacemos. Nos comportamos de manera ética, inclusiva y responsable para un futuro mejor.
Apoyamos a nuestros clientes en la resolución de desafíos críticos. Operamos a lo largo de todo el ciclo de vida del proyecto, desde el diseño conceptual, la ingeniería, la adquisición y construcción hasta la operación y mantenimiento de las instalaciones.
Clientes, socios y comunidades confían en MOSS porque estamos aquí para el largo plazo, entregando proyectos exitosos tanto de escala como de importancia durante más de un siglo. Desde la chispa de una idea hasta la finalización de un proyecto, nuestros casi 27.000 colegas en más de 60 ubicaciones alrededor del mundo ofrecen soluciones profesionales y técnicas con una experiencia de primer nivel.